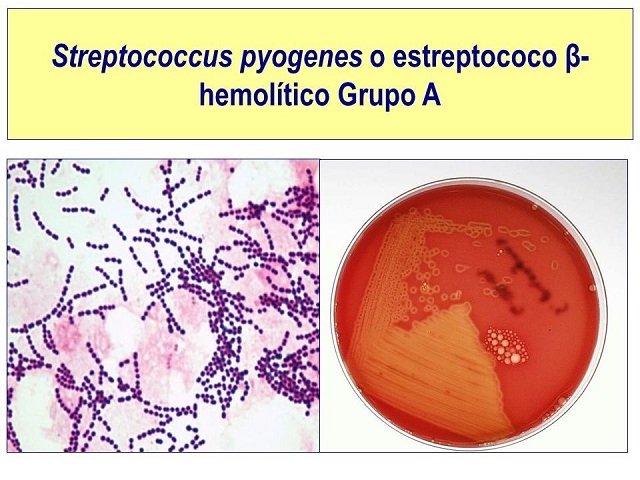

El mensaje fue dirigido desde el Colegio San Benito de Nurcia a las familias, cuyas autoridades decidieron cerrar el establecimiento por 48 horas según indican las medidas sanitarias ante estos casos.
El mensaje fue dirigido desde el Colegio San Benito de Nurcia a las familias, cuyas autoridades decidieron cerrar el establecimiento por 48 horas según indican las medidas sanitarias ante estos casos.
De esta manera entonces se confirma en Mercedes un caso de esta bacteria que tiene atemorizado a todo el país y que ya se cobró seis víctimas fatales, la mayoría de ellos en niños y el caso de un adulto de 38 años. Es un alumnos que concurre a sala de cinco años que estaría afectado por la bacteria Estreptococo Beta Hemolítico Grupo A.
Si bien todavía no se conocen detalles certeros del caso, el mensaje de la escuela señala que el niño se encuentra asistido, aunque se desconoce también si permanece en la ciudad o fue trasladado a un centro hospitalario de Capital Federal. Es por eso que para evitar posibles contagios, se decidió cerrar el colegio por dos días, para que se puedan llevar a cabo acciones de prevención primarias como lo indiquen las autoridades correspondientes.
Esta noticia aparecida en las redes fue comunicada por Cecilia Falabella, directiva del mismo, lo que causó alto impacto en la comunidad por los temores que está causando esta bacteria que se ha cobrado seis vidas.




